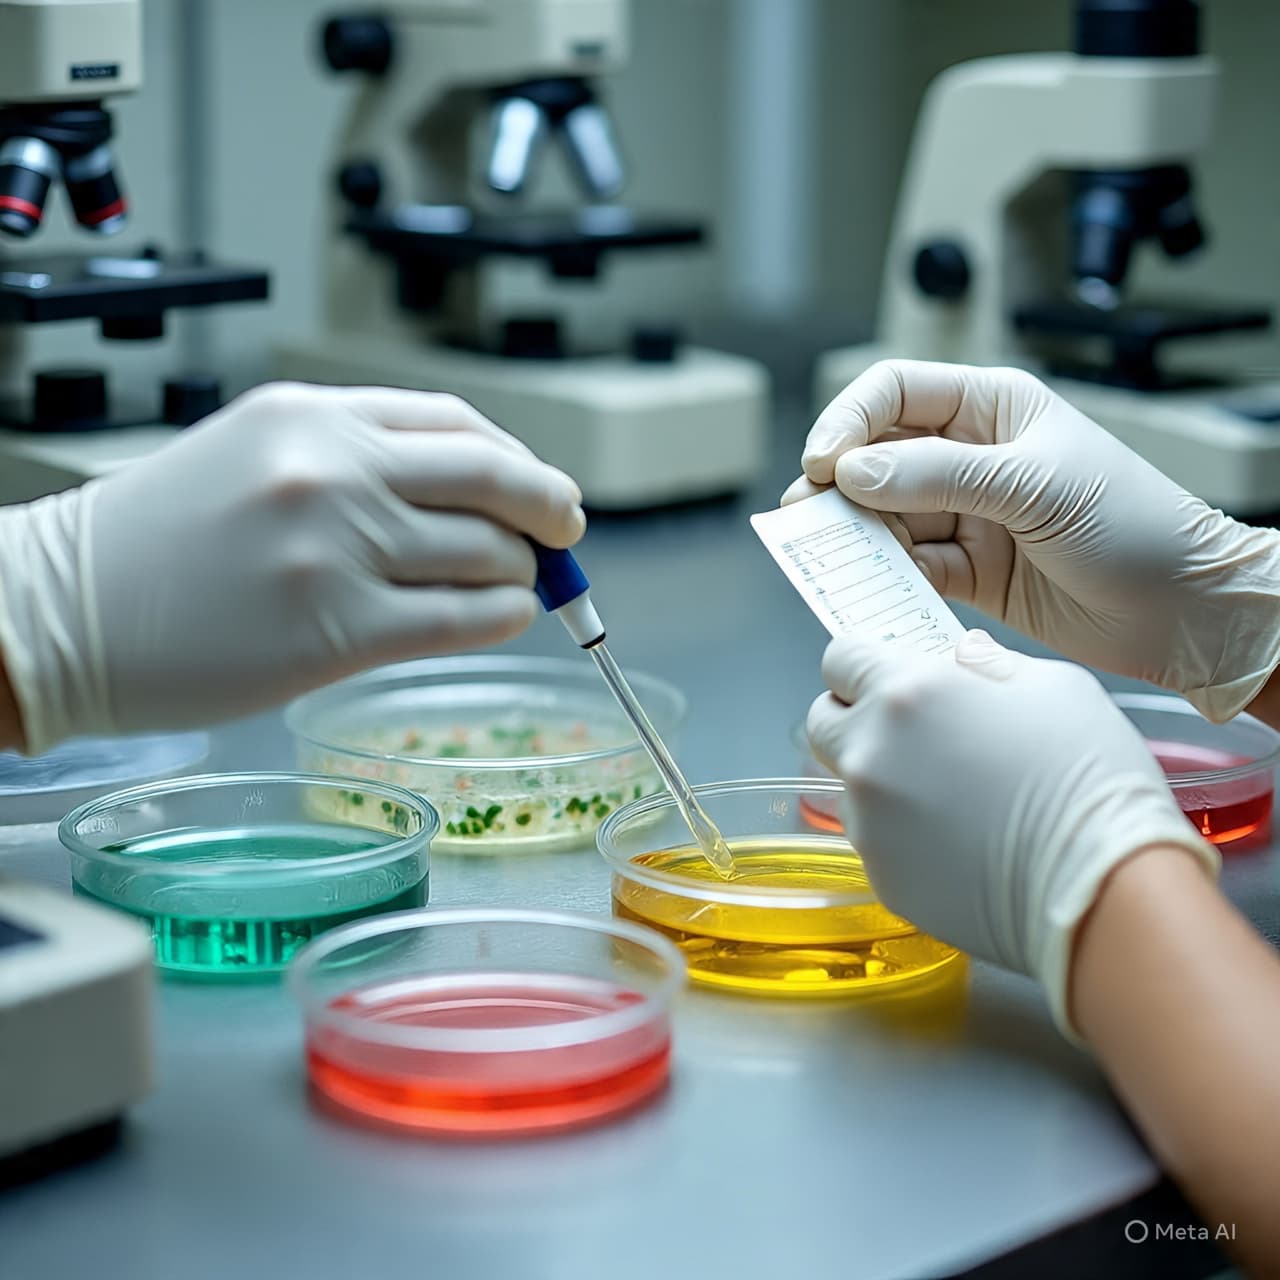
The Taste of Time, the Shadow of Doubt: Reflections on a Dairy Recall

Morning settles quietly over pastureland, where the rhythm of farming usually unfolds in small, predictable gestures—hands at work, milk drawn at dawn, the slow transformation of liquid into something aged and patient. In such places, time often feels measured not in headlines, but in seasons. Yet even here, where the air carries the scent of grass and fermentation, disruption can arrive invisibly, carried not by noise but by something microscopic, drifting through what once felt certain.
It was in this quiet space of routine that concern began to gather. A raw dairy farm, known for its unpasteurized cheeses and traditional methods, has issued a recall of its cheddar products, linking them to a cluster of nine E. coli infections. The recall, described by the farm as being made “under protest,” carries with it a tone of reluctance—an acknowledgment of responsibility intertwined with a defense of longstanding practices.
Unpasteurized, or “raw,” dairy products have long existed at the intersection of craft and caution. Advocates speak of flavor, of heritage, of microbial complexity that mirrors the land itself. Critics, meanwhile, point to the risks—bacteria that can move quietly from environment to table, sometimes with consequences that only become visible after the fact. In this tension, the story of the recalled cheddar finds its place, not as an isolated event but as part of a broader conversation that has lingered for decades.
Health authorities traced the infections back to the farm’s products after individuals in multiple locations reported illness consistent with E. coli exposure. Symptoms, often severe, can include abdominal pain, diarrhea, and in some cases complications that extend beyond the digestive system. While most recover, the presence of even a small number of cases tends to ripple outward, prompting investigations, advisories, and the careful retracing of supply chains.
The farm’s response reflects this uneasy balance. By recalling the cheese, it enters the formal language of public health—compliance, precaution, containment. Yet the phrasing of “under protest” suggests a parallel narrative, one in which the farm questions the findings or the processes that led to them. It hints at a deeper friction between regulatory frameworks and artisanal identity, between the impulse to preserve tradition and the imperative to protect consumers.
Across the wider landscape of food production, such moments are not unfamiliar. They surface whenever systems built on trust—between producer and consumer, between method and safety—are tested by uncertainty. In the case of raw dairy, that trust often rests on invisible thresholds: temperature, sanitation, microbial balance. When those thresholds shift, even slightly, the effects can travel far beyond the boundaries of a single farm.
For those affected, the story is less abstract. It is measured in days of illness, in hospital visits, in the disruption of ordinary life. For retailers and distributors, it becomes a logistical exercise—products pulled from shelves, notices issued, inventories checked. And for regulators, it reinforces the ongoing challenge of overseeing a food system that is both deeply modern and, in pockets, deliberately rooted in older ways.
As the recall unfolds, the facts settle into place with quiet clarity. Nine confirmed E. coli cases have been linked to the cheddar. The dairy farm has removed the product from circulation while investigations continue. Health authorities are advising consumers to avoid the affected cheese and to monitor for symptoms if they have already consumed it.
In the end, the pasture remains, the routines return, and the process of making cheese will likely continue—adjusted, examined, perhaps contested. But for a moment, the stillness of that landscape has been interrupted, reminding us that even the most familiar rituals carry within them a delicate balance, where care, tradition, and unseen forces meet.
AI Image Disclaimer Illustrations were created using AI tools and are not real photographs.
Sources : Reuters Centers for Disease Control and Prevention U.S. Food and Drug Administration Associated Press World Health Organization